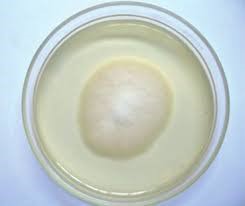

¿Cuál es la diferencia principal entre una bacteria fitopatógena y un fitoplasma ?
El fitoplasma es un parasito obligado que solo puede sobrevivir si se encuentra en el interior de las plantas, ya que estos se alimentan del floema de las plantas. Se caracterizan por la falta de pared celular y porque no pueden ser cultivados. Sus vectores principales son los insectos.
Diga si es verdadero o falso (tiene 2 minutos para responderla):
Los patógenos biótrofos tiene un rango de hospedero estrecho y atacan tejidos jóvenes, débiles o senescentes.
falso, atacan cualquier tipo de tejido.
Explique en que se basa el modelo de gen por gen
Por cada gen que confiere virulencia al patógeno hay un gen correspondiente que confiere resistencia en el hospedero y viceversa.
Mencione 4 métodos para el control de fitopatógenos.
Control físico, químico, biológico y manejo integrado de plagas.
Se presento afectación en un cultivo de fresas en donde se presencio una cubierta aterciopelada gris en las partes necróticas de las hojas, las frutas presentan deterioro y pudrición causada por micelio fúngico .Se puede observar en la siguiente imagen la afectación de las fresas y de las plantas:


AL realizar una microscopia se observó lo siguiente:

¿ Cuál es el posible fitopatógeno que está generando esto y justifíquelo ?
Botrytis cinerea
¿Cuál es la diferencia de susceptibilidad y resistencia y que tipos de resistencia existen?
La susceptibilidad hace referencia a la incapacidad de la planta a contrarrestar un patógeno y la resistencia es la habilidad de contrarrestar la enfermedad y la resistencia pueden ser horizontales o verticales.
¿Qué agentes bióticos y abióticos pueden ser agente causal de una enfermedad en plantas
Como agentes bióticos podemos tener, virus, bacterias, hongos, nematodos. Como factores abióticos tenemos: salinidad, sequedad, humedad relativa, deficiencia de nutrientes.
¿ Cuál es la desventaja de la resistencia vertical o cualitativa?
Es una defensa fácilmente burlada por el patógeno debido a que solo necesita una mutación en un gen para que esta saltada.
Mencione cuales son las principales aplicaciones del sistema de secreción tipo 4 en biotecnología.
Es usado principalmente para crear plantas resistentes a ciertos fitopatógenos ya que se les puede transferir genes de resistencia específicos.
En un cultivo de tomate se presentó una producción baja con respecto a las cosechas pasadas, al examinar el cultivo se evidencio síntomas y signos que apuntaban a un agente biotico como causante. Esto debido a que se preguntó sobre cambios repentinos en las condiciones ambientales o en los fertilizantes y no se presentaron cambios. Las características del cultivo fueron siguientes:
Síntomas y signos: Amarillamiento en las hojas, con mayor incidencia en la hoja que se encuentran en la parte alta de las plantas, marchitamiento, y al realizar un corte longitudinal en el tallo se observó lo siguiente:

Condiciones ambientales: Humedad alta, temperaturas entre 15° y 25°C
Morfología colonial y microscopia:
¿ Cual es el posible fitopatógeno que esta generando esto y justifíquelo ?
Fusarium spp.
¿ Cuales son los postulados de koch ( enfocado a las plantas)?
1.El patógeno del cual se esta sospechando debe estar asociado constantemente a plantas enferma
2.El patógeno del cual se esta sospechando debe ser asilado a un medio de cultivo y debe ser caracterizado.
3. La enfermedad debe reproducirse en plantas sanas inoculadas con el organismo aislado
4. El mismo organismo caracterizado en el punto 2 debe ser nuevamente aislado a partir de las plantas inoculadas en el punto 3
¿Cuál es el sistema de secreción usado por Agrobacterium tumefaciuns para transferir material genético? ¿Y qué tipo de material genético es transferido?
El sistema de secreción es el tipo 4 y se transfiere tDNA a la célula huésped.
Diga si es F o V. La resistencia monogénica sólo genera resistencia contra una especie del patógeno.
Verdad
Explique la estrategia (cultivos trampas) para controlar plantas parasitas
Cultivos trampa y cultivos cebo: los cultivos trampa producen una germinación de la especie parásita por estimulación de sus exudados radiculares, y si no posibilitan su instalación radicular producen un descenso en las reservas de semilla de jopo. Cabe destacar el maíz, el sorgo y el lino. De forma similar, los cultivos cebo producen la germinación de la especie parásita y también su instalación.
En un cultivo de soja que presentaba clorosis en las hojas, y en los tallos, acompañado con necrosis en la raíz se encontró presencia de quistes como se muestra en la imagen:

¿Que tipo de agente causal tiene esta planta ( Ejemplo especie, endo, ecto, sedentario...?
Heterodera sp , Endoparásito sedentario
Diga varias maneras de saber que la causa de la enfermedad no es un factor abiotico.
-Su distribucion dentro del cultivo
-El tiempo que lleva desarrollandose
-Encontrar estructuras de el agente causal.
Mencione tres estructuras de defensa histológica en las plantas
Capas de corcho inducidas por hongos, bacterias, virus y nematodos; capas de absición en hojas jóvenes; tilosis en xilema; depósitos de goma.
¿Cuál molécula es usada por las plantas para activar el estado de alerta sistemático en caso de ataque de un patógeno necrótrofo?
Jasmonato
¿Cuáles son las posibles razones para que los agricultores no utilicen el control biológico en sus cultivos?
Es costoso, necesita ser aplicado varias veces, no confían en este tipo de métodos, no es eficaz para eliminar el patógeno.
Se presenta enanismo en un cultivo de girasoles como se muestra a continuacion:

Concluya sobre el agente causal y justifique como probaría que este es el que genera esto.
Un virus, aplicar los postulados de koch.
¿Cuál es el género y que estructura fúngica es la culpable de generar la enfermedad ergotismo que se da por un agente fúngico que contamina el centeno, avena, el trigo y la cebada? Adicionalmente este puede llegar a causar alucinaciones, convulsiones y que puede ocasionar necrosis en los tejidos.
Claviceps purpurea, ya que este genera micotoxinas que pueden contener LSD. El consumo de estas micotoxinas se puede generar esta enfermedad.
Usted es un investigador de plagas en plantas, en una de sus salidas de campo mediante observación se da cuenta que la transmisión de un virus presenta los siguientes valores: la adquisición se da en aproximadamente 57 segundos, la inoculación se da en aproximadamente 2 minutos y la retención del virus en el vector tiene un tiempo promedio de 2,4 horas. ¿En base a lo anterior, a qué tipo de virus se está enfrentado usted como investigador?
El investigador se está enfrentando a un tipo de virus con transmisión no persistente
¿Cuál es el dominio de la quinasa sintetizada por el gen R?
dominio LRR
¿Cómo se llama el mecanismo de defensa que usan los insectos contra hongos entomopatógenos y en qué consiste?
Melanización, es el proceso mediante el cual el insecto produce melanina que rodea e inactivan hongos entomopatógenos.
Si usted observa la imagen a continuación:

Podria concluir cual es el agente causal de la enfermedad.¿si, no?, ¿si se puede cual seria?
Un factor abiótico, debido a que las lesiones observadas son localizadas y no se observa que se esté esparciendo. Esto se dio por la aplicación de fertilizantes no apropiada.